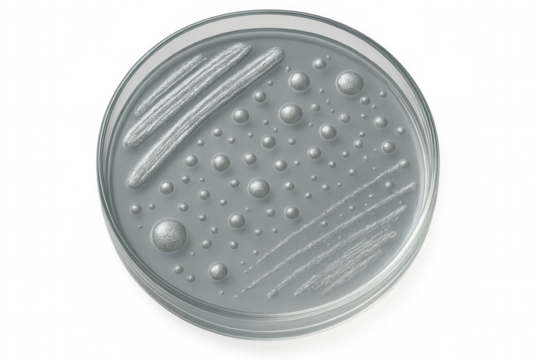
Metallic silver bacteria growing and multiplying on petri dish with transparent background, viewed from above

- Home >
- Stock PNGs >
- Transparent Metallic DNA Structure on White Background
Transparent Metallic DNA Structure on White Background PNG

This illustration depicts a stylized transparent metallic DNA double helix against a white background. The sleek, chrome-like design gives a futuristic and modern feel, suitable for scientific presentations, biotechnology company branding, and educational materials about genetics. Its abstract nature makes it versatile for use in technology-related artworks or as a background feature for discussions on genetic engineering.
0
downloads
downloads
Tags:
More
Credit Photo
If you would like to credit the Photo, here are some ways you can do so
Text Link
png Link
<span class="text-link">
<span>
<a target="_blank" href=https://pikwizard.com/png/transparent-metallic-dna-structure-on-white-background/d0257886eb47ee3bc02cc699146b05a3/>PikWizard</a>
</span>
</span>
<span class="image-link">
<span
style="margin: 0 0 20px 0; display: inline-block; vertical-align: middle; width: 100%;"
>
<a
target="_blank"
href="https://pikwizard.com/png/transparent-metallic-dna-structure-on-white-background/d0257886eb47ee3bc02cc699146b05a3/"
style="text-decoration: none; font-size: 10px; margin: 0;"
>
<img src="https://pikwizard.com/pw/medium/d0257886eb47ee3bc02cc699146b05a3.png" style="margin: 0; width: 100%;" alt="" />
<p style="font-size: 12px; margin: 0;">PikWizard</p>
</a>
</span>
</span>
Free (free of charge)
Free for personal and commercial use.
Author: Authentic Images